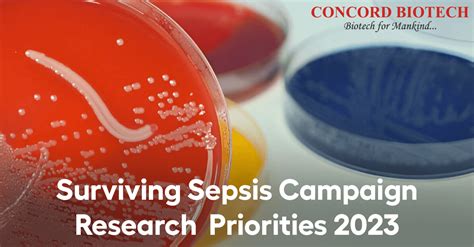

Surviving Sepsis Campaign 2023: Key Updates
Surviving Sepsis Campaign 2023: Key Updates
Hey everyone! So, the big news in the critical care world is the release of the Surviving Sepsis Campaign guidelines for 2023 . It’s a massive update, guys, and it’s crucial for anyone dealing with sepsis, from docs and nurses on the front lines to even us folks who just want to understand more about this life-threatening condition. These guidelines are basically the roadmap for how we should be treating sepsis, and the 2023 version brings some really important refinements and new recommendations. We’re talking about everything from how we identify sepsis early to the nitty-gritty of fluid resuscitation, vasopressors, and even mechanical ventilation strategies. It’s a complex topic, for sure, but understanding these updates can literally be the difference between life and death for patients. So, grab a coffee, settle in, and let’s break down what’s new and why it matters.
Table of Contents
Early Recognition and Diagnosis: The First Critical Steps
One of the most significant focuses of the 2023 Surviving Sepsis Campaign guidelines is on earlier and more accurate recognition and diagnosis of sepsis. You know, time is absolutely of the essence when it comes to sepsis. The faster we can spot it and start treatment, the better the outcomes. The updated guidelines really double down on using clinical criteria and scoring systems to help identify patients at high risk. They’re pushing for a more standardized approach, encouraging healthcare providers to be vigilant and not to dismiss subtle signs. Think about it: what might seem like a mild infection could actually be the start of something much more serious. The guidelines emphasize the importance of a low threshold for suspicion, especially in vulnerable populations like the elderly, immunocompromised individuals, or those with chronic illnesses. They also highlight the role of biomarkers, like procalcitonin and lactate, not just for diagnosis but also for monitoring treatment response. It’s not just about if a patient has sepsis, but how severe it is and how well they’re responding to therapy. We’re seeing a stronger push towards integrating rapid diagnostic tools and ensuring that the diagnostic process doesn’t delay the initiation of essential treatments like antibiotics and fluid resuscitation. The goal here is to reduce the time from symptom onset to definitive care, minimizing the damage that sepsis can inflict on the body’s organs. This early recognition isn’t just a nice-to-have; it’s a fundamental pillar of effective sepsis management , and the 2023 guidelines make that abundantly clear. They’re trying to equip clinicians with better tools and a sharper mindset to catch sepsis in its tracks, before it spirals out of control and leads to septic shock or multi-organ failure. It’s a complex dance between clinical suspicion, diagnostic testing, and prompt intervention, and these updated guidelines aim to make that dance more coordinated and effective.
Fluid Resuscitation: Getting the Balance Right
When we talk about sepsis management , fluid resuscitation is a cornerstone , and the 2023 Surviving Sepsis Campaign guidelines offer some refined advice here. The general principle of administering intravenous fluids to patients with sepsis and suspected hypoperfusion hasn’t changed – it’s still a critical early step. However, the nuances are key. The guidelines reiterate the importance of early and adequate fluid administration, typically with crystalloids like normal saline or Lactated Ringer’s. The goal is to restore intravascular volume and improve tissue perfusion. But here’s where it gets interesting: it’s not just about drowning patients in fluids. The updated recommendations emphasize the need for dynamic assessment of fluid responsiveness . This means looking at how a patient’s hemodynamics (like blood pressure and heart rate) respond to fluid administration, rather than just blindly pushing fluids. Think about using tools like passive leg raises or pulse pressure variation in ventilated patients to predict whether they will actually benefit from more fluids. Over-resuscitation can be just as harmful as under-resuscitation, potentially leading to fluid overload, pulmonary edema, and increased workload for the heart. So, it’s a delicate balancing act. The guidelines also touch upon the type of fluids used. While crystalloids remain the first choice, there’s ongoing discussion and some nuanced recommendations regarding the use of balanced crystalloids (like Lactated Ringer’s) over normal saline, especially in large volumes, due to concerns about hyperchloremic acidosis with normal saline. The emphasis is on tailoring the fluid strategy to the individual patient, considering their underlying conditions and response to therapy. Monitoring kidney function, electrolytes, and fluid balance becomes paramount. It’s about being judicious with fluids, ensuring that we’re giving enough to perfuse vital organs but not so much that we cause harm. This refined approach to fluid resuscitation highlights the move towards more personalized and physiology-guided therapy in sepsis care. It’s not a one-size-fits-all approach, and the 2023 guidelines are steering us in that direction, reminding us that while fluids are life-saving, their administration needs to be both timely and smart . This careful consideration of fluid administration is crucial for optimizing outcomes and preventing complications associated with sepsis.
Vasopressor Therapy: Restoring Blood Pressure
For patients who remain hypotensive despite adequate fluid resuscitation, vasopressor therapy is the next critical intervention , and the 2023 Surviving Sepsis Campaign guidelines provide updated recommendations on its use. The primary goal of vasopressors in sepsis is to restore and maintain adequate mean arterial pressure (MAP) to ensure perfusion of vital organs. The guidelines reaffirm norepinephrine as the first-line vasopressor of choice for septic shock. It’s a workhorse because it provides both alpha-adrenergic (vasoconstriction) and beta-adrenergic (inotropic) effects, helping to increase blood pressure and cardiac output. If norepinephrine alone is insufficient to achieve the target MAP, the guidelines now offer a more refined approach to adding other agents. Vasopressin is recommended as a second-line agent to increase MAP and potentially decrease the required dose of norepinephrine, thereby reducing the risk of arrhythmias associated with high-dose norepinephrine. Dopamine is generally reserved for specific situations, such as patients with a very high risk of arrhythmias or severe bradycardia, as it carries a higher risk of side effects compared to norepinephrine. The guidelines also provide more specific guidance on target MAP . While historical targets were often around 65 mmHg, the 2023 updates suggest a more individualized approach, considering factors like baseline blood pressure and the presence of comorbidities. For patients without a history of chronic hypertension, a target MAP of 65 mmHg is generally recommended. However, for those with chronic hypertension, a higher target MAP (e.g., 70-75 mmHg) might be necessary to ensure adequate cerebral perfusion. The emphasis is on using vasopressors judiciously and titrating them based on the patient’s response, aiming to achieve adequate organ perfusion rather than just a number on the monitor. Continuous hemodynamic monitoring is essential to guide titration and assess the effectiveness of therapy. Furthermore, the guidelines highlight the importance of addressing the underlying cause of sepsis and optimizing other aspects of care, such as fluid status and ventilation, which can influence the response to vasopressors. It’s a complex interplay, and these updated recommendations aim to provide clinicians with a clearer, evidence-based framework for using vasopressors effectively and safely to combat the devastating effects of septic shock. The focus remains on achieving the right balance to support circulation without causing undue harm.
Mechanical Ventilation Strategies: Breathing Easier
When patients with sepsis develop acute respiratory distress syndrome (ARDS) or respiratory failure, mechanical ventilation becomes a critical part of their care , and the 2023 Surviving Sepsis Campaign guidelines offer important updates in this area. The overarching principle remains lung-protective ventilation, a strategy that has significantly improved outcomes in ARDS. This means using a low tidal volume (typically 4-8 mL/kg of ideal body weight) and a moderate respiratory rate to minimize the risk of ventilator-induced lung injury (VILI). The 2023 guidelines reinforce this approach, emphasizing its importance in reducing mortality and duration of mechanical ventilation. They also provide more specific guidance on PEEP (positive end-expiratory pressure) titration. Instead of a one-size-fits-all approach, the guidelines suggest using higher PEEP levels in moderate to severe ARDS to improve oxygenation and lung recruitment, while carefully monitoring for adverse effects like hemodynamic compromise. The concept of recruitment maneuvers is also discussed, with recommendations for their use in select patients with severe ARDS to help open up collapsed alveoli, although caution is advised due to potential risks. For patients with sepsis-induced ARDS, proning (placing the patient on their stomach) is strongly recommended for those with moderate to severe ARDS who are receiving mechanical ventilation. Prone positioning can improve oxygenation by redistributing ventilation-perfusion and recruiting dorsal lung regions. The guidelines also address sedation and analgesia, emphasizing the need for lighter sedation and daily sedation interruptions to facilitate early assessment of neurological status and readiness for liberation from mechanical ventilation. Minimizing sedation can help reduce the duration of mechanical ventilation and the risk of delirium. Finally, the guidelines touch upon weaning from mechanical ventilation, encouraging early assessment of readiness to weathe and implementing appropriate weaning protocols. It’s all about getting patients off the ventilator as soon as it’s safe and feasible, reducing the risks associated with prolonged mechanical ventilation. These updated ventilation strategies underscore the commitment to evidence-based, patient-centered care in managing the respiratory complications of sepsis, aiming to optimize lung function while minimizing ventilator-induced harm.
Other Key Considerations and Future Directions
Beyond the core areas of recognition, fluids, vasopressors, and ventilation, the 2023 Surviving Sepsis Campaign guidelines also touch upon several other crucial aspects of sepsis management and point towards future research directions. One significant area is the role of antibiotic stewardship . While prompt administration of broad-spectrum antibiotics is vital in the early hours of sepsis, the guidelines also stress the importance of de-escalating therapy once a specific pathogen is identified and sensitivities are known. This helps combat antimicrobial resistance and reduces the risk of C. difficile infections. They encourage the use of diagnostic tools to guide antibiotic selection and duration, moving away from unnecessarily prolonged or overly broad therapy. Another important point is the management of circulatory support beyond vasopressors . For patients with refractory shock, the guidelines discuss the potential role of other advanced therapies, such as extracorporeal membrane oxygenation (ECMO) or mechanical circulatory support devices, though these are typically reserved for highly specialized centers and specific patient populations. The guidelines also emphasize the importance of glycemic control . While tight glycemic control was once advocated, the current recommendations suggest a more moderate approach, aiming for blood glucose levels below 180 mg/dL (10 mmol/L) in most adult patients, with careful monitoring to avoid hypoglycemia. This reflects a shift towards a less aggressive stance on glucose management in critical illness. Furthermore, the 2023 guidelines acknowledge the growing body of evidence regarding the use of adjunctive therapies , such as corticosteroids, although their role remains nuanced and is generally recommended for specific subgroups of patients with septic shock who are refractory to fluids and vasopressors. The guidelines also highlight areas where more research is desperately needed. This includes understanding the long-term consequences of sepsis (post-sepsis syndrome), optimizing the management of sepsis in special populations (like pregnant women or children), and developing novel diagnostic and therapeutic strategies. The Surviving Sepsis Campaign is a living document, constantly evolving as new evidence emerges. These 2023 updates are a testament to that, pushing the envelope in sepsis care and setting the stage for further advancements. It’s an ongoing effort to improve outcomes for patients facing this devastating condition, and staying abreast of these guidelines is absolutely essential for all healthcare professionals involved in critical care.
In conclusion, the Surviving Sepsis Campaign guidelines 2023 represent a significant step forward in how we approach and manage this complex and life-threatening illness. They reinforce the critical importance of early recognition, refine our strategies for fluid resuscitation and vasopressor use, and provide updated guidance on mechanical ventilation. Coupled with a strong emphasis on antibiotic stewardship and a forward-looking approach to other management aspects, these guidelines offer a comprehensive framework for clinicians. Remember guys, staying updated with these guidelines isn’t just about ticking a box; it’s about providing the best possible care to patients battling sepsis. Keep learning, keep adapting, and let’s continue the fight against sepsis together!